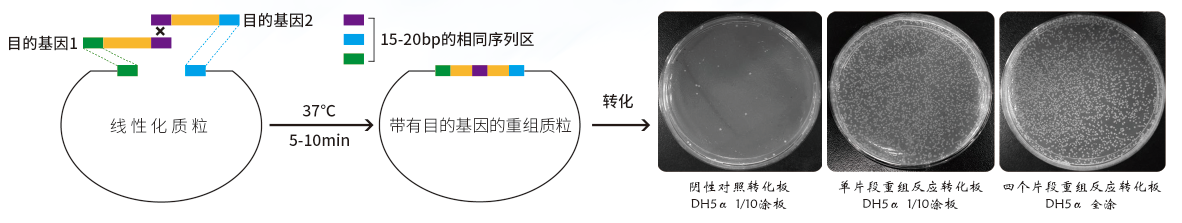
1744181370262.jpg

購零背景載體、無縫克隆送手機、手表、水杯、耳機、MatePad Air
冰爽夏日·好禮相送
◆ 多 ◆ 快 ◆ 好 ◆ 省之載體、無縫克隆
買1送1 多買多送 手機、手表、水杯、耳機、平板驚喜好禮等您拿!
促銷截止時間:2025年5月31日
—————————————— 完美替代T載體、平端載體等 —————————————
| 貨號 | 名稱 | 規(guī)格 | 價格 | 促銷價 |
ZC233-1 | SE無縫克隆和組裝試劑盒II(一管式無縫克隆)4×SE Cloning Mix | 20次 贈10支感受態(tài) 1支F5 Mix | 600 | 買1送1 |
ZC233-2 | 60次 贈30支感受態(tài) 3支F5 Mix | 1500 |
產(chǎn)品簡介:簡單、快速并且高效的DNA定向克隆,插入1-5個片段PCR產(chǎn)物定向克隆至任意載體的任意位點。
產(chǎn)品特點:
◆ 快速:一管式操作,5-10分鐘完成載體構建。
◆ 高效:陽性克隆率99%以上。
◆ 片段范圍:15bp-12Kb,小片段尤其適宜RNA干擾。
◆ 靈活:克隆位點可在載體的任意位置。
◆ 低 濃 度:1Kb以下DNA片段濃度低至1ng。
◆ 精確:不會增加任何額外的序列。
實驗數(shù)據(jù):

◆ 通用性強:平端,粘端通用 ◆
| 貨號 | 名稱 | 規(guī)格 | 價格 | 促銷價 |
ZC206-1 | 20次 贈10支感受態(tài) 1支F5 Mix | 760 | 買1送1 | |
ZC206-2 | 60次 贈30支感受態(tài) 3支F5 Mix | 2000 |
產(chǎn)品特點:
多
長斑數(shù)多。
快
一管式加樣,室溫5min連接。
好
陽性率高〉99%陽性率,可用于大片段(測試成功12KB)。
省
實際使用次數(shù)多 20T=40T 60T=120T(5μl體系) 。
ZC206、ZC233滿贈活動

滿:1盒60T
贈:星巴克櫻花春綻系列雙飲口不銹鋼杯680ml水杯

滿:2盒60T
贈:第六季自助餐廳券或JBL T770NC 無線藍牙耳機

滿:5盒60T
贈:華為HUAWEI WATCH GT 5 幻夜黑46mm華為智能手表

滿:10盒60T
贈:HUAWEI MatePad Air 12英寸2024款華為平板電腦2.8K全面屏

滿:20盒60T
贈:華為 Pocket 2 12GB+512GB手機
注:以上禮品僅供參考,兌換以實物為準。
質(zhì)粒庫
擁有萬余種質(zhì)粒供您選擇所有質(zhì)粒均可提供測序報告。





